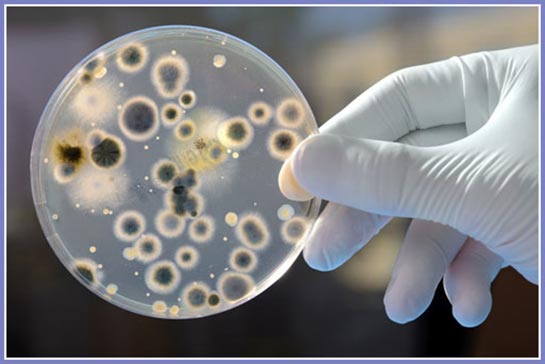

İngiltere’deki McDonalds, Burger King ve KFC restoranlarındaki içeceklerde dışkıda bulunan bakteri saptandı. BBC’de yayımlanan Watchdog isimli program her zaman yaptığı gibi restorandan topladığı 10 numuneyi test laboratuvarlarına gönderdi ve çarpıcı sonuçları ekrana yansıttı.

Peş peşe açıklamalar
McDonald’s’tan alınan üç numunede Burger King’den alınan altı numunede ve KFC’den alınan 7 numunede koliform bakterisi saptandı. KFC’den konuyla ilgili yapılan açıklamada, “Şok içindeyiz ciddi hayal kırıklığı yaşıyoruz” açıklamasında bulunuldu. Burger King, “Temizlik ve hijyen önceliğimizdir” derken CNBC’ye konuşan McDonald’s yetkilileri, “Bizim için insan sağlığından daha önemlisi yok” diye konuştu.
Koliform nedir?
Koliform bakteriler gıda ve suların sıhhi durumunu gösteren göstergeç bakterileri olarak tanımlanıyor. Koliformlar sıcak kanlı hayvanların dışkılarında bolca bulunurlar, ama sulak ortamlarda, toprakta ve bitkilerde de bulunurlar. Çoğu zaman kloliformalar kendileri hastalığa neden olmazlar ama kolay kültürlenirler, ve varlıkları dışkı kaynaklı zararlı patojenlerin de mevcut olabileceğine işaret edebilir.














